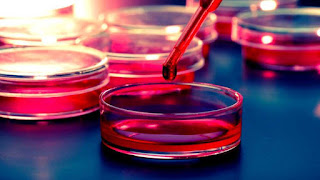

Stem-cell therapy is the use of stem cells to treat or prevent a disease or condition.
Bone marrow transplant is the most widely used stem-cell therapy, but some therapies derived from umbilical cord blood are also in use. Research is underway to develop various sources for stem cells, and to apply stem-cell treatments for neurodegenerative diseases and conditions such as diabetes, heart disease, and other conditions.
Stem-cell therapy has become controversial following developments such as the ability of scientists to isolate and culture embryonic stem cells, to create stem cells using somatic cell nuclear transfer and their use of techniques to create induced pluripotent stem cells. This controversy is often related to abortion politics and to human cloning. Additionally, efforts to market treatments based on transplant of stored umbilical cord blood have been controversial.
Video Stem-cell therapy
Medical uses
For over 30 years, bone marrow has been used to treat cancer patients with conditions such as leukaemia and lymphoma; this is the only form of stem-cell therapy that is widely practiced. During chemotherapy, most growing cells are killed by the cytotoxic agents. These agents, however, cannot discriminate between the leukaemia or neoplastic cells, and the hematopoietic stem cells within the bone marrow. It is this side effect of conventional chemotherapy strategies that the stem-cell transplant attempts to reverse; a donor's healthy bone marrow reintroduces functional stem cells to replace the cells lost in the host's body during treatment. The transplanted cells also generate an immune response that helps to kill off the cancer cells; this process can go too far, however, leading to graft vs host disease, the most serious side effect of this treatment.
Another stem-cell therapy called Prochymal, was conditionally approved in Canada in 2012 for the management of acute graft-vs-host disease in children who are unresponsive to steroids. It is an allogenic stem therapy based on mesenchymal stem cells (MSCs) derived from the bone marrow of adult donors. MSCs are purified from the marrow, cultured and packaged, with up to 10,000 doses derived from a single donor. The doses are stored frozen until needed.
The FDA has approved five hematopoietic stem-cell products derived from umbilical cord blood, for the treatment of blood and immunological diseases.
In 2014, the European Medicines Agency recommended approval of limbal stem cells for people with severe limbal stem cell deficiency due to burns in the eye.
Maps Stem-cell therapy
Research
Stem cells are being studied for a number of reasons. The molecules and exosomes released from stem cells are also being studied in an effort to make medications. The paracrine soluble factors produced by stem cells, known as the stem cell secretome, has been found to be the predominant mechanism by which stem cell-based therapies mediate their effects in degenerative, auto-immune and inflammatory diseases.
Applications
Neurodegeneration
Research has been conducted on the effects of stem cells on animal models of brain degeneration, such as in Parkinson's, Amyotrophic lateral sclerosis, and Alzheimer's disease. There have been preliminary studies related to multiple sclerosis.
Healthy adult brains contain neural stem cells which divide to maintain general stem-cell numbers, or become progenitor cells. In healthy adult laboratory animals, progenitor cells migrate within the brain and function primarily to maintain neuron populations for olfaction (the sense of smell). Pharmacological activation of endogenous neural stem cells has been reported to induce neuroprotection and behavioral recovery in adult rat models of neurological disorder.
Brain and spinal cord injury
Stroke and traumatic brain injury lead to cell death, characterized by a loss of neurons and oligodendrocytes within the brain. Clinical and animal studies have been conducted into the use of stem cells in cases of spinal cord injury.
Heart
Stems cells are being studied in those with severe heart disease.
The work by Bodo-Eckehard Strauer has been discredited by the identification of hundreds of factual contradictions. Among several clinical trials that have reported that adult stem-cell therapy is safe and effective, powerful effects have been reported from only a few laboratories, infarcts as well as heart failure not arising from myocardial infarction. While initial animal studies demonstrated therapeutic effects, later clinical trials achieved only modest, though statistically significant, improvements.
Stem-cell therapy for treatment of myocardial infarction usually makes use of autologous bone-marrow stem cells (a specific type or all), however other types of adult stem cells may be used, such as adipose-derived stem cells. Adult stem cell therapy for treating heart disease was commercially available in at least five continents as of 2007.
Possible mechanisms of recovery include:
- Generation of heart muscle cells
- Stimulation of growth of new blood vessels to repopulate damaged heart tissue
- Secretion of growth factors
- Assistance via some other mechanism
It may be possible to have adult bone-marrow cells differentiate into heart muscle cells.
The first successful integration of human embryonic stem cell derived cardiomyocytes in guinea pigs (mouse hearts beat too fast) was reported in August 2012. The contraction strength was measured four weeks after the guinea pigs underwent simulated heart attacks and cell treatment. The cells contracted synchronously with the existing cells, but it is unknown if the positive results were produced mainly from paracrine as opposed to direct electromechanical effects from the human cells. Future work will focus on how to get the cells to engraft more strongly around the scar tissue. Whether treatments from embryonic or adult bone marrow stem cells will prove more effective remains to be seen.
In 2013 the pioneering reports of powerful beneficial effects of autologous bone marrow stem cells on ventricular function were found to contain "hundreds" of discrepancies. Critics report that of 48 reports there seemed to be just five underlying trials, and that in many cases whether they were randomized or merely observational accepter-versus-rejecter, was contradictory between reports of the same trial. One pair of reports of identical baseline characteristics and final results, was presented in two publications as, respectively, a 578 patient randomized trial and as a 391 patient observational study. Other reports required (impossible) negative standard deviations in subsets of patients, or contained fractional patients, negative NYHA classes. Overall there were many more patients published as having receiving stem cells in trials, than the number of stem cells processed in the hospital's laboratory during that time. A university investigation, closed in 2012 without reporting, was reopened in July 2013.
One of the most promising benefits of stem cell therapy is the potential for cardiac tissue regeneration to reverse the tissue loss underlying the development of heart failure after cardiac injury.
Blood-cell formation
The specificity of the human immune-cell repertoire is what allows the human body to defend itself from rapidly adapting antigens. However, the immune system is vulnerable to degradation upon the pathogenesis of disease, and because of the critical role that it plays in overall defense, its degradation is often fatal to the organism as a whole. Diseases of hematopoietic cells are diagnosed and classified via a subspecialty of pathology known as hematopathology. The specificity of the immune cells is what allows recognition of foreign antigens, causing further challenges in the treatment of immune disease. Identical matches between donor and recipient must be made for successful transplantation treatments, but matches are uncommon, even between first-degree relatives. Research using both hematopoietic adult stem cells and embryonic stem cells has provided insight into the possible mechanisms and methods of treatment for many of these ailments.
Fully mature human red blood cells may be generated ex vivo by hematopoietic stem cells (HSCs), which are precursors of red blood cells. In this process, HSCs are grown together with stromal cells, creating an environment that mimics the conditions of bone marrow, the natural site of red-blood-cell growth. Erythropoietin, a growth factor, is added, coaxing the stem cells to complete terminal differentiation into red blood cells. Further research into this technique should have potential benefits to gene therapy, blood transfusion, and topical medicine.
Regrowing teeth
In 2004, scientists at King's College London discovered a way to cultivate a complete tooth in mice and were able to grow bioengineered teeth stand-alone in the laboratory. Researchers are confident that the tooth regeneration technology can be used to grow live teeth in human patients.
In theory, stem cells taken from the patient could be coaxed in the lab turning into a tooth bud which, when implanted in the gums, will give rise to a new tooth, and would be expected to be grown in a time over three weeks. It will fuse with the jawbone and release chemicals that encourage nerves and blood vessels to connect with it. The process is similar to what happens when humans grow their original adult teeth. Many challenges remain, however, before stem cells could be a choice for the replacement of missing teeth in the future.
Cochlear hair cell regrowth
Heller has reported success in re-growing cochlea hair cells with the use of embryonic stem cells.
Blindness and vision impairment
Since 2003, researchers have successfully transplanted corneal stem cells into damaged eyes to restore vision. "Sheets of retinal cells used by the team are harvested from aborted fetuses, which some people find objectionable." When these sheets are transplanted over the damaged cornea, the stem cells stimulate renewed repair, eventually restore vision. The latest such development was in June 2005, when researchers at the Queen Victoria Hospital of Sussex, England were able to restore the sight of forty patients using the same technique. The group, led by Sheraz Daya, was able to successfully use adult stem cells obtained from the patient, a relative, or even a cadaver. Further rounds of trials are ongoing.
Pancreatic beta cells
Diabetes patients lose the function of insulin-producing beta cells within the pancreas. In recent experiments, scientists have been able to coax embryonic stem cell to turn into beta cells in the lab. In theory if the beta cell is transplanted successfully, they will be able to replace malfunctioning ones in a diabetic patient.
Orthopaedics
Clinical case reports in the treatment orthopaedic conditions have been reported. To date, the focus in the literature for musculoskeletal care appears to be on mesenchymal stem cells. Centeno et al. have published MRI evidence of increased cartilage and meniscus volume in individual human subjects. The results of trials that include a large number of subjects, are yet to be published. However, a published safety study conducted in a group of 227 patients over a 3-4-year period shows adequate safety and minimal complications associated with mesenchymal cell transplantation.
Wakitani has also published a small case series of nine defects in five knees involving surgical transplantation of mesenchymal stem cells with coverage of the treated chondral defects.
Wound healing
Stem cells can also be used to stimulate the growth of human tissues. In an adult, wounded tissue is most often replaced by scar tissue, which is characterized in the skin by disorganized collagen structure, loss of hair follicles and irregular vascular structure. In the case of wounded fetal tissue, however, wounded tissue is replaced with normal tissue through the activity of stem cells. A possible method for tissue regeneration in adults is to place adult stem cell "seeds" inside a tissue bed "soil" in a wound bed and allow the stem cells to stimulate differentiation in the tissue bed cells. This method elicits a regenerative response more similar to fetal wound-healing than adult scar tissue formation. Researchers are still investigating different aspects of the "soil" tissue that are conducive to regeneration.
Infertility
Culture of human embryonic stem cells in mitotically inactivated porcine ovarian fibroblasts (POF) causes differentiation into germ cells (precursor cells of oocytes and spermatozoa), as evidenced by gene expression analysis.
Human embryonic stem cells have been stimulated to form Spermatozoon-like cells, yet still slightly damaged or malformed. It could potentially treat azoospermia.
In 2012, oogonial stem cells were isolated from adult mouse and human ovaries and demonstrated to be capable of forming mature oocytes. These cells have the potential to treat infertility.
HIV/AIDS
Destruction of the immune system by the HIV is driven by the loss of CD4+ T cells in the peripheral blood and lymphoid tissues. Viral entry into CD4+ cells is mediated by the interaction with a cellular chemokine receptor, the most common of which are CCR5 and CXCR4. Because subsequent viral replication requires cellular gene expression processes, activated CD4+ cells are the primary targets of productive HIV infection. Recently scientists have been investigating an alternative approach to treating HIV-1/AIDS, based on the creation of a disease-resistant immune system through transplantation of autologous, gene-modified (HIV-1-resistant) hematopoietic stem and progenitor cells (GM-HSPC).
Clinical trials
Regenerative treatment models
Stem cells are thought to mediate repair via five primary mechanisms: 1) providing an anti-inflammatory effect, 2) homing to damaged tissues and recruiting other cells, such as endothelial progenitor cells, that are necessary for tissue growth, 3) supporting tissue remodeling over scar formation, 4) inhibiting apoptosis, and 5) differentiating into bone, cartilage, tendon, and ligament tissue.
To further enrich blood supply to the damaged areas, and consequently promote tissue regeneration, platelet-rich plasma could be used in conjunction with stem cell transplantation. The efficacy of some stem cell populations may also be affected by the method of delivery; for instance, to regenerate bone, stem cells are often introduced in a scaffold where they produce the minerals necessary for generation of functional bone.
Stem cells have also been shown to have a low immunogenicity due to the relatively low number of MHC molecules found on their surface. In addition, they have been found to secrete chemokines that alter the immune response and promote tolerance of the new tissue. This allows for allogeneic treatments to be performed without a high rejection risk.
Drug discovery and biomedical research
The ability to grow up functional adult tissues indefinitely in culture through Directed differentiation creates new opportunities for drug research. Researchers are able to grow up differentiated cell lines and then test new drugs on each cell type to examine possible interactions in vitro before performing in vivo studies. This is critical in the development of drugs for use in veterinary research because of the possibilities of species specific interactions. The hope is that having these cell lines available for research use will reduce the need for research animals used because effects on human tissue in vitro will provide insight not normally known before the animal testing phase.
- With the advent of induced pluripotent stem cells (iPSC), treatments being explored and created for the used in endangered low production animals possible. Rather than needing to harvest embryos or eggs, which are limited, the researchers can remove mesenchymal stem cells with greater ease and greatly reducing the danger to the animal due to noninvasive techniques. This allows the limited eggs to be put to use for reproductive purposes only.
Conservation
Stem cells are being explored for use in conservation efforts. Spermatogonial stem cells have been harvested from a rat and placed into a mouse host and fully mature sperm were produced with the ability to produce viable offspring. Currently research is underway to find suitable hosts for the introduction of donor spermatogonial stem cells. If this becomes a viable option for conservationists, sperm can be produced from high genetic quality individuals who die before reaching sexual maturity, preserving a line that would otherwise be lost.
Sources for stem cells
Most stem cells intended for regenerative therapy are generally isolated either from the patient's bone marrow or from adipose tissue. Mesenchymal stem cells can differentiate into the cells that make up bone, cartilage, tendons, and ligaments, as well as muscle, neural and other progenitor tissues, they have been the main type of stem cells studied in the treatment of diseases affecting these tissues. The number of stem cells transplanted into damaged tissue may alter efficacy of treatment. Accordingly, stem cells derived from bone marrow aspirates, for instance, are cultured in specialized laboratories for expansion to millions of cells. Although adipose-derived tissue also requires processing prior to use, the culturing methodology for adipose-derived stem cells is not as extensive as that for bone marrow-derived cells. While it is thought that bone-marrow derived stem cells are preferred for bone, cartilage, ligament, and tendon repair, others believe that the less challenging collection techniques and the multi-cellular microenvironment already present in adipose-derived stem cell fractions make the latter the preferred source for autologous transplantation.
New sources of mesenchymal stem cells are being researched, including stem cells present in the skin and dermis which are of interest because of the ease at which they can be harvested with minimal risk to the animal. Hematopoetic stem cells have also been discovered to be travelling in the blood stream and possess equal differentiating ability as other mesenchymal stem cells, again with a very non-invasive harvesting technique.
- There has been more recent interest in the use of extra embryonic mesenchymal stem cells. Research is underway to examine the differentiating capabilities of stem cells found in the umbilical cord, yolk sac and placenta of different animals. These stem cells are thought to have more differentiating ability than their adult counterparts, including the ability to more readily form tissues of endodermal and ectodermal origin.
Embryonic stem cell lines
There is widespread controversy over the use of human embryonic stem cells. This controversy primarily targets the techniques used to derive new embryonic stem cell lines, which often requires the destruction of the blastocyst. Opposition to the use of human embryonic stem cells in research is often based on philosophical, moral, or religious objections. There is other stem cell research that does not involve the destruction of a human embryo, and such research involves adult stem cells, amniotic stem cells, and induced pluripotent stem cells.
On 23 January 2009, the US Food and Drug Administration gave clearance to Geron Corporation for the initiation of the first clinical trial of an embryonic stem-cell-based therapy on humans. The trial aimed evaluate the drug GRNOPC1, embryonic stem cell-derived oligodendrocyte progenitor cells, on patients with acute spinal cord injury. The trial was discontinued in November 2011 so that the company could focus on therapies in the "current environment of capital scarcity and uncertain economic conditions". In 2013 biotechnology and regenerative medicine company BioTime (AMEX: BTX) acquired Geron's stem cell assets in a stock transaction, with the aim of restarting the clinical trial.
Mesenchymal stromal cells (MSCs)
Scientists have reported that MSCs when transfused immediately within few hours post thawing may show reduced function or show decreased efficacy in treating diseases as compared to those MSCs which are in log phase of cell growth(fresh), so cryopreserved MSCs should be brought back into log phase of cell growth in invitro culture before these are administered for clinical trials or experimental therapies, re-culturing of MSCs will help in recovering from the shock the cells get during freezing and thawing. Various clinical trials on MSCs have failed which used cryopreserved product immediately post thaw as compared to those clinical trials which used fresh MSCs.
Veterinary medicine
Research has been conducted on horses, dogs, and cats can benefit the development of stem cell treatments in veterinary medicine and can target a wide range of injuries and diseases such as myocardial infarction, stroke, tendon and ligament damage, osteoarthritis, osteochondrosis and muscular dystrophy both in large animals, as well as humans. While investigation of cell-based therapeutics generally reflects human medical needs, the high degree of frequency and severity of certain injuries in racehorses has put veterinary medicine at the forefront of this novel regenerative approach. Companion animals can serve as clinically relevant models that closely mimic human disease.
Sources of stem cells
Veterinary applications of stem cell therapy as a means of tissue regeneration have been largely shaped by research that began with the use of adult-derived mesenchymal stem cells to treat animals with injuries or defects affecting bone, cartilage, ligaments and/or tendons. There are two main categories of stem cells used for treatments: allogeneic stem cells derived from a genetically different donor within the same species and autologous mesenchymal stem cells, derived from the patient prior to use in various treatments. A third category, xenogenic stem cells, or stem cells derived from different species, are used primarily for research purposes, especially for human treatments.
Hard-tissue repair
Bone has a unique and well documented natural healing process that normally is sufficient to repair fractures and other common injuries. Misaligned breaks due to severe trauma, as well as things like tumor resections of bone cancer, are prone to improper healing if left to the natural process alone. Scaffolds composed of natural and artificial components are seeded with mesenchymal stem cells and placed in the defect. Within four weeks of placing the scaffold, newly formed bone begins to integrate with the old bone and within 32 weeks, full union is achieved. Further studies are necessary to fully characterize the use of cell-based therapeutics for treatment of bone fractures.
Stem cells have been used to treat degenerative bone diseases. The normally recommended treatment for dogs that have Legg-Calve-Perthes disease is to remove the head of the femur after the degeneration has progressed. Recently, mesenchymal stem cells have been injected directly in to the head of the femur, with success not only in bone regeneration, but also in pain reduction.
Because of the general positive healing capabilities of stem cells, they have gained interest for the treatment of cutaneous wounds. This is important interest for those with reduced healing capabilities, like diabetics and those undergoing chemotherapy. In one trial, stem cells were isolated from the Wharton's jelly of the umbilical cord. These cells were injected directly into the wounds. Within a week, full re-epithelialization of the wounds had occurred, compared to minor re-epithelialization in the control wounds. This showed the capabilities of mesenchymal stem cells in the repair of epidermal tissues.
Soft-palate defects in horses are caused by a failure of the embryo to fully close at the midline during embryogenesis. These are often not found until after they have become worse because of the difficulty in visualizing the entire soft palate. This lack of visualization is thought to also contribute to the low success rate in surgical intervention to repair the defect. As a result, the horse often has to be euthanized. Recently, the use of mesenchymal stem cells has been added to the conventional treatments. After the surgeon has sutured the palate closed, autologous mesenchymal cells are injected into the soft palate. The stem cells were found to be integrated into the healing tissue especially along the border with the old tissue. There was also a large reduction in the number of inflammatory cells present, which is thought to aid in the healing process.
Ligament and tendon repair
Autologous stem cell-based treatments for ligament injury, tendon injury, osteoarthritis, osteochondrosis, and sub-chondral bone cysts have been commercially available to practicing veterinarians to treat horses since 2003 in the United States and since 2006 in the United Kingdom. Autologous stem cell based treatments for tendon injury, ligament injury, and osteoarthritis in dogs have been available to veterinarians in the United States since 2005. Over 3000 privately owned horses and dogs have been treated with autologous adipose-derived stem cells. The efficacy of these treatments has been shown in double-blind clinical trials for dogs with osteoarthritis of the hip and elbow and horses with tendon damage.
Race horses are especially prone to injuries of the tendon and ligaments. Conventional therapies are very unsuccessful in returning the horse to full functioning potential. Natural healing, guided by the conventional treatments, leads to the formation of fibrous scar tissue that reduces flexibility and full joint movement. Traditional treatments prevented a large number of horses from returning to full activity and also have a high incidence of re-injury due to the stiff nature of the scarred tendon. Introduction of both bone marrow and adipose derived stem cells, along with natural mechanical stimulus promoted the regeneration of tendon tissue. The natural movement promoted the alignment of the new fibers and tendocytes with the natural alignment found in uninjured tendons. Stem cell treatment not only allowed more horses to return to full duty and also greatly reduced the re-injury rate over a three-year period.
The use of embryonic stem cells has also been applied to tendon repair. The embryonic stem cells were shown to have a better survival rate in the tendon as well as better migrating capabilities to reach all areas of damaged tendon. The overall repair quality was also higher, with better tendon architecture and collagen formed. There was also no tumor formation seen during the three-month experimental period. Long-term studies need to be carried out to examine the long-term efficacy and risks associated with the use of embryonic stem cells. Similar results have been found in small animals.
Joint repair
Osteoarthritis is the main cause of joint pain both in animals and humans. Horses and dogs are most frequently affected arthritis. Natural cartilage regeneration is very limited and no current drug therapies are curative, but rather look to reduce the symptoms associated with the degeneration. Different types of mesenchymal stem cells and other additives are still being researched to find the best type of cell and method for long-term treatment.
Adipose-derived mesenchymal cells are currently the most often used because of the non-invasive harvesting. There has been a lot of success recently injecting mesenchymal stem cells directly into the joint. This is a recently developed, non-invasive technique developed for easier clinical use. Dogs receiving this treatment showed greater flexibility in their joints and less pain.
Muscle repairs
Stem cells have successfully been used to ameliorate healing in the heart after myocardial infarction in dogs. Adipose and bone marrow derived stem cells were removed and induced to a cardiac cell fate before being injected into the heart. The heart was found to have improved contractility and a reduction in the damaged area four weeks after the stem cells were applied.
A different trial is underway for a patch made of a porous substance onto which the stem cells are "seeded" in order to induce tissue regeneration in heart defects. Tissue was regenerated and the patch was well incorporated into the heart tissue. This is thought to be due, in part, to improved angiogenesis and reduction of inflammation. Although cardiomyocytes were produced from the mesenchymal stem cells, they did not appear to be contractile. Other treatments that induced a cardiac fate in the cells before transplanting had greater success at creating contractile heart tissue.
Nervous system repairs
Spinal cord injuries are one of the most common traumas brought into veterinary hospitals. Spinal injuries occur in two ways after the trauma: the primary mechanical damage, and in secondary processes, like inflammation and scar formation, in the days following the trauma. These cells involved in the secondary damage response secrete factors that promote scar formation and inhibit cellular regeneration. Mesenchymal stem cells that are induced to a neural cell fate are loaded onto a porous scaffold and are then implanted at the site of injury. The cells and scaffold secrete factors that counteract those secreted by scar forming cells and promote neural regeneration. Eight weeks later, dogs treated with stem cells showed immense improvement over those treated with conventional therapies. Dogs treated with stem cells were able to occasionally support their own weight, which has not been seen in dogs undergoing conventional therapies.
Treatments are also in clinical trials to repair and regenerate peripheral nerves. Peripheral nerves are more likely to be damaged, but the effects of the damage are not as widespread as seen in injuries to the spinal cord. Treatments are currently in clinical trials to repair severed nerves, with early success. Stem cells induced to a neural fate injected in to a severed nerve. Within four weeks, regeneration of previously damaged stem cells and completely formed nerve bundles were observed.
Stem cells are also in clinical phases for treatment in ophthalmology. Hematopoietic stem cells have been used to treat corneal ulcers of different origin of several horses. These ulcers were resistant to conventional treatments available, but quickly responded positively to the stem cell treatment. Stem cells were also able to restore sight in one eye of a horse with retinal detachment, allowing the horse to return to daily activities.
Keratoconjunctivitis Sicca (KCS)
Pre-clinical models of Sjögrens syndrome have culminated in allogeneic MSCs implanted around the lacrimal glands in KSC dogs that were refractory to current therapy. Significantly improved scores in ocular discharge, conjunctival hyperaemia, corneal changes and Schirmer tear tests (STT) were seen.
Around the world
China
Stem-cell research and treatment was practiced in the People's Republic of China. The Ministry of Health of the People's Republic of China has permitted the use of stem-cell therapy for conditions beyond those approved of in Western countries. The Western World has scrutinized China for its failed attempts to meet international documentation standards of these trials and procedures.
South Korea
In 2005, South Korean scientists claimed to have generated stem cells that were tailored to match the recipient. Each of the 11 new stem cell lines was developed using somatic cell nuclear transfer (SCNT) technology. The resultant cells were thought to match the genetic material of the recipient, thus suggesting minimal to no cell rejection.
Thailand
As of 2013, Thailand still considers Hematopoietic stem cell transplants as experimental. Kampon Sriwatanakul began with a clinical trial in October 2013 with 20 patients. 10 are going to receive stem-cell therapy for Type-2 diabetes and the other 10 will receive stem-cell therapy for emphysema. Chotinantakul's research is on Hematopoietic cells and their role for the hematopoietic system function in homeostasis and immune response.
See also
- Autologous stem-cell transplantation
- Cardiovascular Cell Therapy Research Network (CCTRN)
- Fetal tissue implant
- Human Stem Cells Institute
- Induced pluripotent stem cell
- Induced stem cells
References
External links
- Fiona Murray PhD, Debora Spar PhD "Bit Player Or Powerhouse? China And Stem-Cell Research", "New England Journal of Medicine" 21 September 2006. (Accessed 30 July 2007)
- Clive Cookson "Generous Staffing And Permissive Laws Aid Asia's Largest Stem Cell Effort", "Scientific American" 27 June 2005. (Accessed 30 July 2007)
- Stem cell research & therapy: types of stem cells and their current uses
Source of the article : Wikipedia